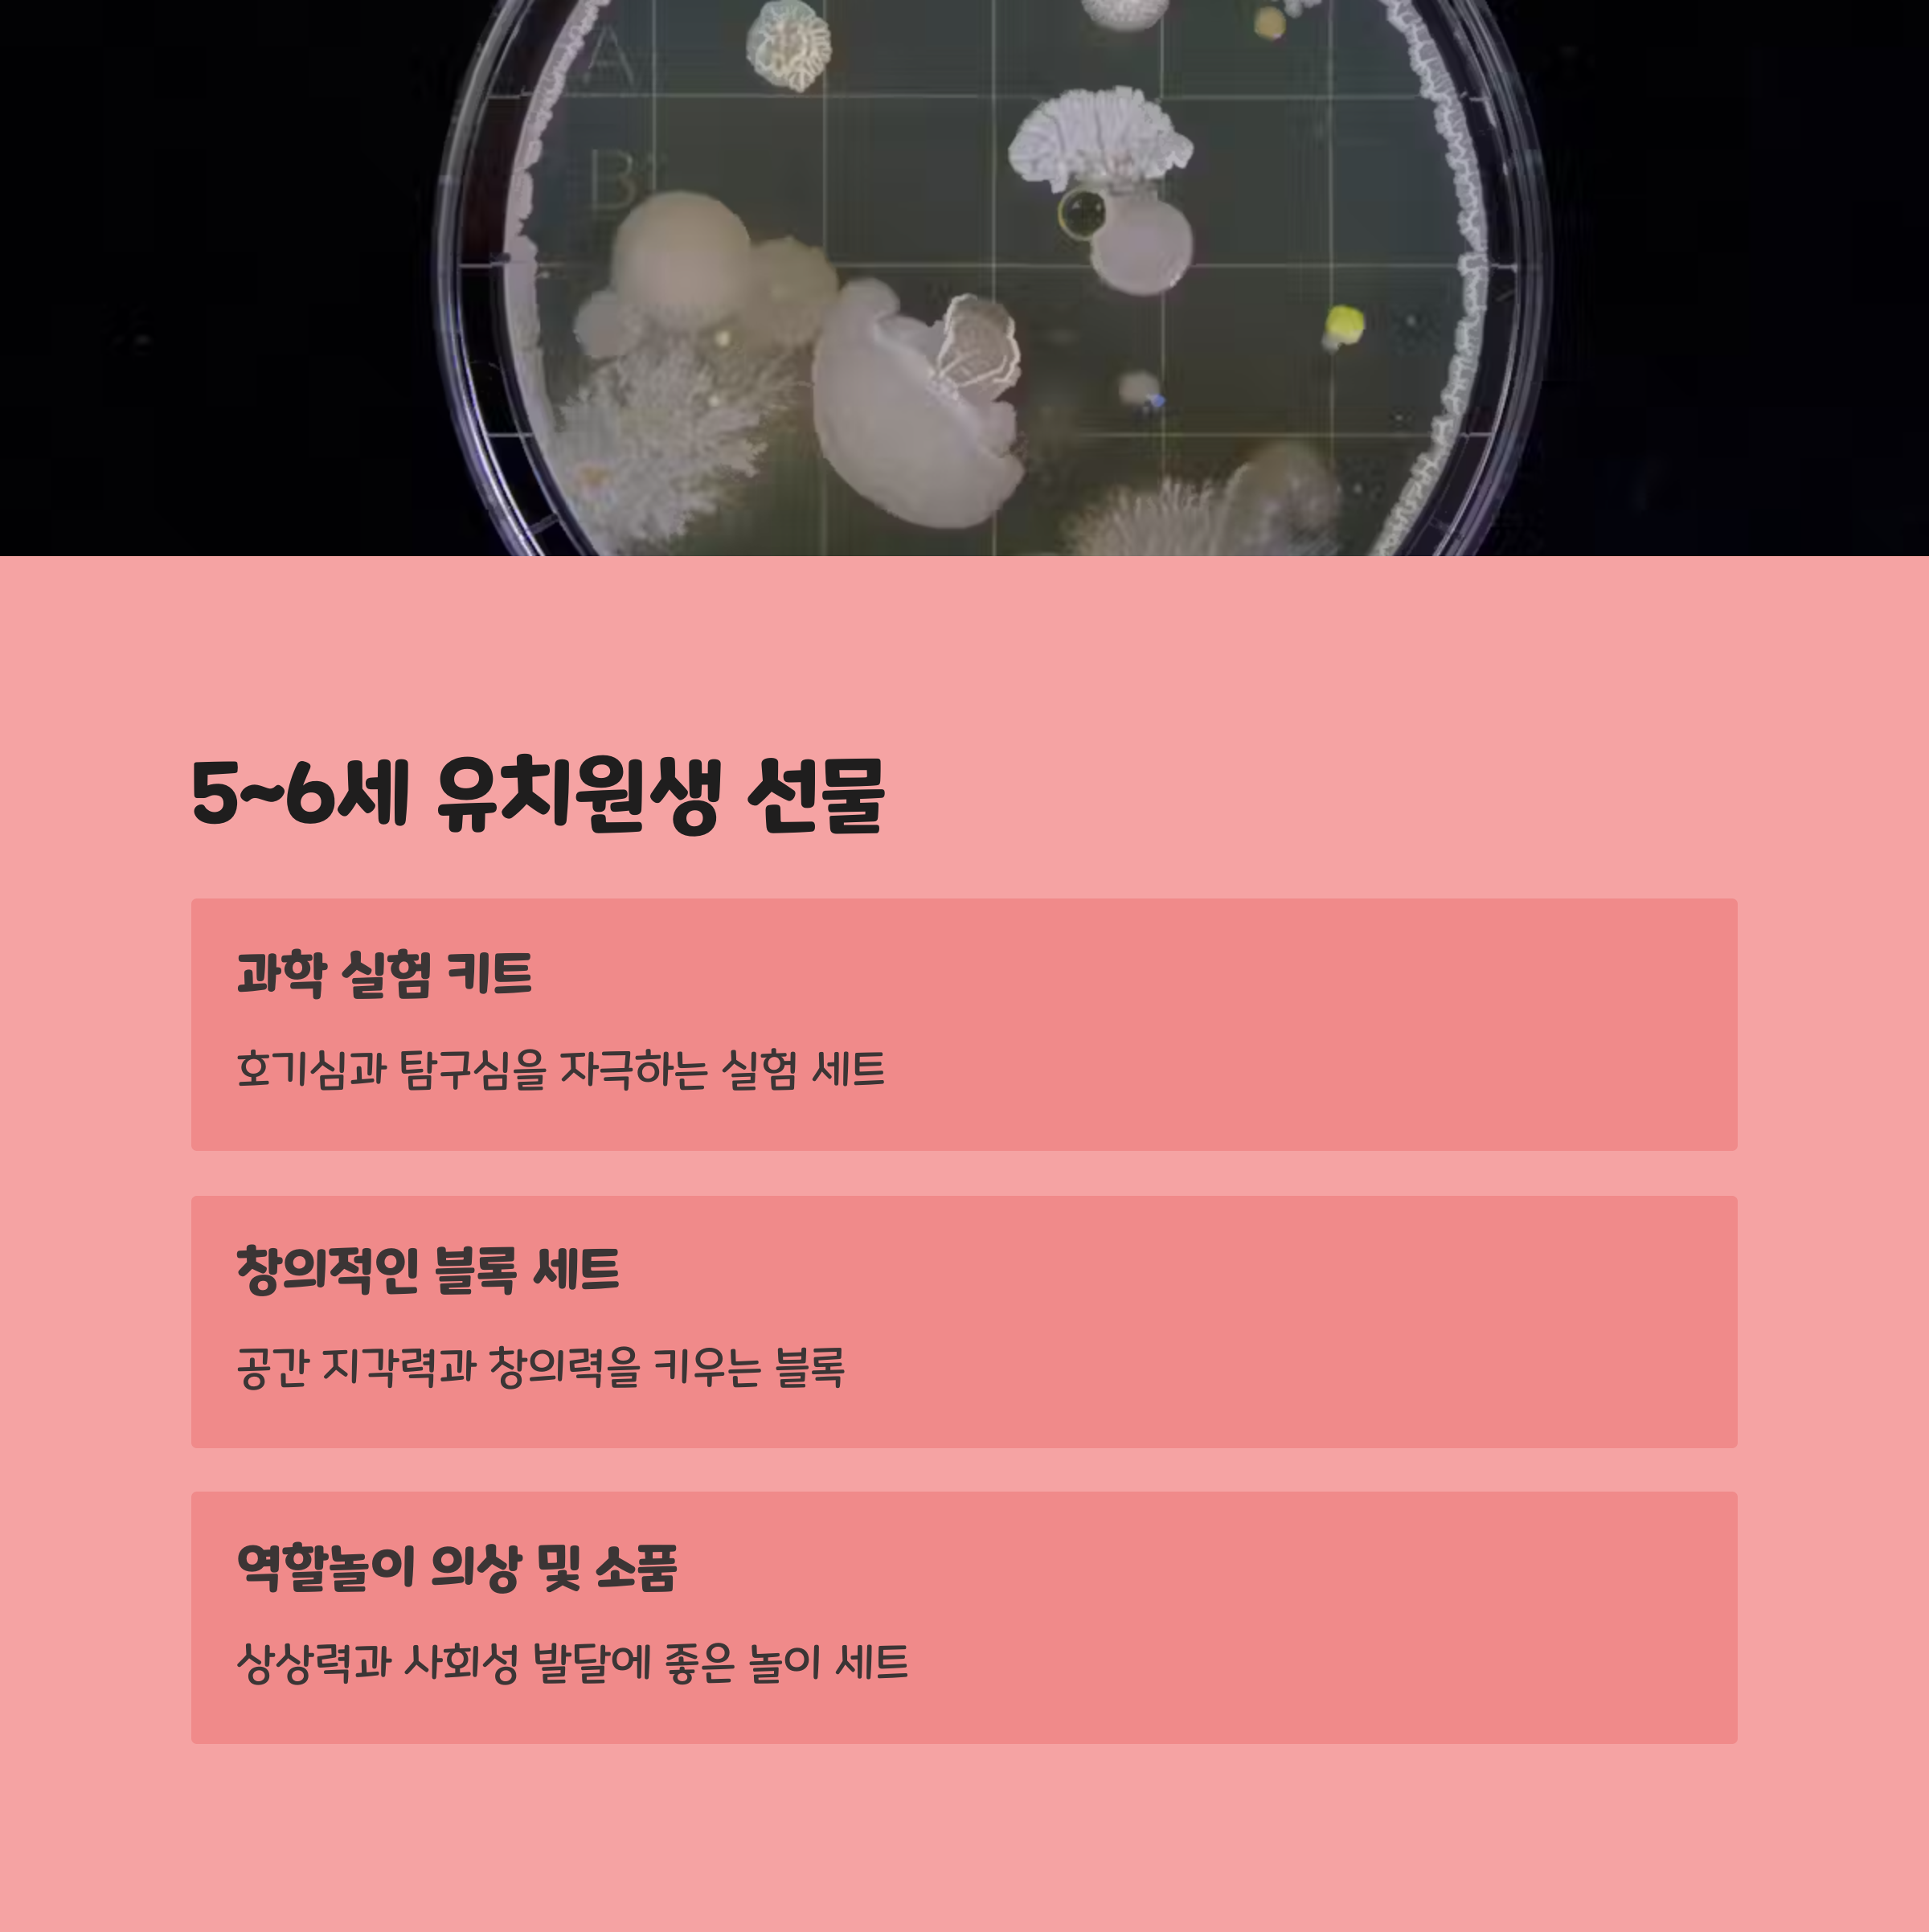

어린이날 나이별 선물 추천 TOP10

5월 5일 어린이날은 아이들에게 꿈과 희망을 심어주는 특별한 날이에요. 이 날을 기념해 선물을 고민 중이라면, 나이별로 아이의 발달 단계에 맞는 맞춤형 선물을 고르는 게 가장 좋아요. 단순한 장난감이 아닌, 아이의 호기심과 창의력을 자극할 수 있는 선물이라면 더욱 뜻깊은 하루가 될 거예요 🎉
‘내 아이에게 맞는 선물은 뭐가 좋을까?’ 고민하는 부모님, 삼촌, 이모, 할머니, 할아버지를 위해! 지금부터 나이대별 어린이날 선물 TOP10을 소개할게요. 참고로 이건 제가 생각했을 때 정말 반응 좋은 선물들로 구성했어요 😎
0~2세 유아용 선물 👶

0~2세 아이들은 세상 모든 것이 새롭고 신기한 시기예요. 이 시기의 선물은 안전성과 감각 자극을 중심으로 선택하는 게 좋아요. 부드럽고 소리나는 헝겊책, 촉감 좋은 인형, 무독성 실리콘 치발기 등은 인기 있는 선택지 중 하나예요.
특히 활동 범위가 점점 넓어지는 1~2세의 경우엔 아기 걸음마 보조기나 미끄럼 방지 매트도 실용적인 선물이 될 수 있어요. 기능성 쪽으로는 자동으로 회전하는 모빌이나 수면등도 육아에 큰 도움이 돼서 부모님에게도 환영받는 선물이에요.
안전 인증이 되어 있는 브랜드 제품인지, 입에 넣어도 괜찮은 소재인지 꼭 확인하고 골라야 해요. 요즘은 캐릭터 IP를 활용한 아기 전용 굿즈들도 많아서, 좋아하는 그림책 캐릭터가 있는 아이라면 그에 맞춘 선물도 좋아요.
이 시기 아이들은 생일도 겹쳐 있는 경우가 많기 때문에, 성장앨범과 같은 기념형 선물도 고려해보면 좋아요. 예쁜 포토북이나 손·발도장을 남길 수 있는 세트는 추억을 남기는 데 큰 역할을 하죠.🎨
🍼 0~2세 유아 선물 TOP5 정리표
| 순위 | 선물 | 이유 |
|---|---|---|
| 1위 | 감각 자극 헝겊책 | 촉감, 시각, 청각 자극 |
| 2위 | 자동 모빌 | 수면 유도, 시각 발달 |
| 3위 | 실리콘 치발기 | 안전한 이앓이 해결 |
| 4위 | 걸음마 보조기 | 운동 능력 향상 |
| 5위 | 기념 포토북 세트 | 성장 기록용 추억 선물 |
이제 막 세상을 배워가는 아기에게는 자극적이지 않으면서도 안전한 놀잇감이 정말 중요해요. 정서 발달을 도와주는 소리 장난감이나 부드러운 인형은 정서 안정에도 도움이 되니까 꼭 고려해보세요 😊
0~2세 유아용 선물 👶
0~2세 아이들은 세상 모든 것이 새롭고 신기한 시기예요. 이 시기의 선물은 안전성과 감각 자극을 중심으로 선택하는 게 좋아요. 부드럽고 소리나는 헝겊책, 촉감 좋은 인형, 무독성 실리콘 치발기 등은 인기 있는 선택지 중 하나예요.
특히 활동 범위가 점점 넓어지는 1~2세의 경우엔 아기 걸음마 보조기나 미끄럼 방지 매트도 실용적인 선물이 될 수 있어요. 기능성 쪽으로는 자동으로 회전하는 모빌이나 수면등도 육아에 큰 도움이 돼서 부모님에게도 환영받는 선물이에요.
안전 인증이 되어 있는 브랜드 제품인지, 입에 넣어도 괜찮은 소재인지 꼭 확인하고 골라야 해요. 요즘은 캐릭터 IP를 활용한 아기 전용 굿즈들도 많아서, 좋아하는 그림책 캐릭터가 있는 아이라면 그에 맞춘 선물도 좋아요.
이 시기 아이들은 생일도 겹쳐 있는 경우가 많기 때문에, 성장앨범과 같은 기념형 선물도 고려해보면 좋아요. 예쁜 포토북이나 손·발도장을 남길 수 있는 세트는 추억을 남기는 데 큰 역할을 하죠.🎨
🍼 0~2세 유아 선물 TOP5 정리표
| 순위 | 선물 | 이유 |
|---|---|---|
| 1위 | 감각 자극 헝겊책 | 촉감, 시각, 청각 자극 |
| 2위 | 자동 모빌 | 수면 유도, 시각 발달 |
| 3위 | 실리콘 치발기 | 안전한 이앓이 해결 |
| 4위 | 걸음마 보조기 | 운동 능력 향상 |
| 5위 | 기념 포토북 세트 | 성장 기록용 추억 선물 |
이제 막 세상을 배워가는 아기에게는 자극적이지 않으면서도 안전한 놀잇감이 정말 중요해요. 정서 발달을 도와주는 소리 장난감이나 부드러운 인형은 정서 안정에도 도움이 되니까 꼭 고려해보세요 😊
3~4세 유아 선물 🧸
3~4세는 호기심이 폭발하는 시기로, 아이의 자율성과 창의성을 키울 수 있는 선물이 좋아요. 블록, 색칠놀이, 역할놀이 장난감은 이 시기 아이들에게 큰 인기를 끌어요. 특히 역할놀이 장난감은 아이의 상상력을 자극해서 사회성을 기르기에도 아주 좋아요.
아이들이 직접 참여하고 탐색할 수 있는 활동형 장난감이 효과적이에요. 예를 들어, 소꿉놀이 세트, 모래놀이 테이블, 전자 드럼 같은 장난감들은 몸도 움직이게 하고 리듬감도 길러줘서 여러모로 유익하죠.
이 시기의 선물은 부모와 아이가 함께 사용할 수 있는 커뮤니케이션 도구가 되기도 해요. 그림책 읽기 세트나 사운드북은 부모가 함께 시간을 보내기에도 딱이랍니다. 거기에 색깔과 숫자 등을 학습할 수 있는 기능까지 있다면 금상첨화예요 🎨
선물 선택 시에는 너무 복잡한 기능보다는 간단하면서 직관적으로 사용할 수 있는 장난감이 좋아요. 아이들이 반복적으로 놀이하면서 익숙함을 느낄 수 있는 구조여야 지루하지 않거든요. 무엇보다 안전 소재 확인은 필수예요!
🎲 3~4세 인기 유아 선물 TOP5
| 순위 | 선물 | 특징 |
|---|---|---|
| 1위 | 소꿉놀이 세트 | 역할놀이로 사회성 발달 |
| 2위 | 대형 블록 | 창의력, 집중력 향상 |
| 3위 | 사운드북 | 청각 자극과 학습 가능 |
| 4위 | 모래놀이 테이블 | 감각 발달과 야외 놀이 |
| 5위 | 전자 드럼 장난감 | 리듬감과 운동성 발달 |
3~4세 아이들은 이제 스스로 무언가를 ‘할 수 있다’는 자신감이 생기기 시작하는 시기라서, 참여형 선물이 굉장히 큰 의미를 가져요. 아이 스스로 놀이를 이끌 수 있게 도와주는 장난감을 선택하면 정말 좋아요 😄
3~4세 유아 선물 🧸

3~4세는 호기심이 폭발하는 시기로, 아이의 자율성과 창의성을 키울 수 있는 선물이 좋아요. 블록, 색칠놀이, 역할놀이 장난감은 이 시기 아이들에게 큰 인기를 끌어요. 특히 역할놀이 장난감은 아이의 상상력을 자극해서 사회성을 기르기에도 아주 좋아요.
아이들이 직접 참여하고 탐색할 수 있는 활동형 장난감이 효과적이에요. 예를 들어, 소꿉놀이 세트, 모래놀이 테이블, 전자 드럼 같은 장난감들은 몸도 움직이게 하고 리듬감도 길러줘서 여러모로 유익하죠.
이 시기의 선물은 부모와 아이가 함께 사용할 수 있는 커뮤니케이션 도구가 되기도 해요. 그림책 읽기 세트나 사운드북은 부모가 함께 시간을 보내기에도 딱이랍니다. 거기에 색깔과 숫자 등을 학습할 수 있는 기능까지 있다면 금상첨화예요 🎨
선물 선택 시에는 너무 복잡한 기능보다는 간단하면서 직관적으로 사용할 수 있는 장난감이 좋아요. 아이들이 반복적으로 놀이하면서 익숙함을 느낄 수 있는 구조여야 지루하지 않거든요. 무엇보다 안전 소재 확인은 필수예요!
🎲 3~4세 인기 유아 선물 TOP5
| 순위 | 선물 | 특징 |
|---|---|---|
| 1위 | 소꿉놀이 세트 | 역할놀이로 사회성 발달 |
| 2위 | 대형 블록 | 창의력, 집중력 향상 |
| 3위 | 사운드북 | 청각 자극과 학습 가능 |
| 4위 | 모래놀이 테이블 | 감각 발달과 야외 놀이 |
| 5위 | 전자 드럼 장난감 | 리듬감과 운동성 발달 |
3~4세 아이들은 이제 스스로 무언가를 ‘할 수 있다’는 자신감이 생기기 시작하는 시기라서, 참여형 선물이 굉장히 큰 의미를 가져요. 아이 스스로 놀이를 이끌 수 있게 도와주는 장난감을 선택하면 정말 좋아요 😄
5~6세 유치원 선물 🎨
5~6세는 언어, 숫자, 창의력 발달이 활발한 시기예요. 이 시기의 아이들은 그림 그리고, 만들기, 퍼즐 풀기처럼 집중력과 사고력을 요구하는 활동을 즐기기 시작해요. 그래서 유치원생에게는 학습과 놀이가 동시에 가능한 선물이 딱이죠!
예를 들어, 색칠놀이북, 점잇기 게임, 스토리텔링 블록 세트는 아이의 논리력과 상상력을 자극해줘요. 또 로봇처럼 움직이는 전자 장난감이나 간단한 디지털 카메라 같은 테크 장난감도 관심을 끌기 좋아요.
이 시기의 아이들은 또래 친구와의 관계를 통해 사회성을 키우는 시기이기도 해서, 함께 놀 수 있는 보드게임이나 가족이랑 할 수 있는 게임도 좋은 선물이에요. 상호작용하면서 규칙을 배우고 협동심도 키울 수 있으니까요.
또한, 유치원생용 학습 워크북이나 알파벳·숫자 놀이 교구는 학교생활을 준비할 수 있는 선물로도 인기가 많아요. 아이가 재미를 느끼면서 자연스럽게 학습할 수 있다는 점에서 많은 부모님이 선호하죠!
🧠 5~6세 유치원 선물 TOP5 리스트
| 순위 | 선물 | 장점 |
|---|---|---|
| 1위 | 컬러링북 + 색연필 세트 | 창의력, 미술 감각 자극 |
| 2위 | 스토리텔링 블록 | 논리적 사고 발달 |
| 3위 | 보드게임 | 사회성, 규칙 학습 |
| 4위 | 아동용 디지털 카메라 | 관찰력, 추억 기록 |
| 5위 | 한글 숫자 놀이 교구 | 기초 학습 습관 형성 |
이 시기의 아이들은 무언가를 ‘완성’하는 경험을 굉장히 중요하게 여겨요. 스스로 만들고 완성하고 칭찬받는 경험은 아이의 자존감을 쑥쑥 키워주기 때문에, 그런 구성의 선물을 추천해요 😍
7~9세 초등 저학년 🎒

초등학교에 입학하면서부터 아이들은 학습 중심으로 바뀌는 생활에 적응해요. 따라서 선물도 학교생활과 연계되면서도 놀이로 이어질 수 있는 것이 좋아요. 너무 공부 중심보다는 ‘재미있는 학습’을 유도하는 게 핵심이에요.
인기 있는 선물로는 코딩 로봇, 전자 독서기, 보드게임, 마인드맵 노트, 일기장 등이 있어요. 디지털 기기에 대한 흥미도 이 시기부터 시작되기 때문에, 사용법이 쉬운 아동용 스마트 워치나 음성 검색 학습기 같은 것도 괜찮아요.
또한, 친구들과 함께하는 활동도 점점 중요해지기 때문에, 간단한 마술 세트나 마술 배우기 책도 흥미로울 수 있어요. 자신만의 장기 하나를 갖는 경험은 아이에게 큰 자신감을 줄 수 있어요 🎩
운동기구도 인기가 많아요. 초등학교 운동장에서 활용 가능한 킥보드, 인라인 스케이트, 어린이 농구골대 같은 아이템도 부모님에게 환영받는 선물 중 하나예요. 건강과 놀이를 동시에 챙길 수 있으니까요!
🛹 초등 저학년 어린이날 선물 TOP5
| 순위 | 선물 | 이유 |
|---|---|---|
| 1위 | 아동용 코딩 로봇 | 논리력, 미래 교육 |
| 2위 | 전자 독서기 | 독서 습관 형성 |
| 3위 | 마술세트 | 자신감, 표현력 강화 |
| 4위 | 킥보드 | 야외 활동 + 운동 |
| 5위 | 마인드맵 노트북 | 생각 정리 습관 |
요즘 아이들은 굉장히 똑똑하고 빠르게 흡수해요. 그래서 단순히 ‘재밌는 것’보다는 ‘도전적이면서 몰입 가능한’ 선물을 주면 진짜 몰입해서 오래 갖고 놀아요. 그런 의미에서 코딩 로봇이나 마술 도구는 초강추해요! 🤖
10~12세 초등 고학년 선물 🧑🚀

10~12세는 논리력과 집중력이 크게 향상되는 시기예요. 아이의 관심사도 점점 세분화되고, 자신만의 취향도 생기기 시작해요. 그래서 초등 고학년에게는 단순한 장난감보다는 창작 활동이나 실용적인 선물이 훨씬 인기가 많답니다.
이 시기 아이들이 좋아하는 선물로는 드론, 초등용 스마트워치, 키보드, 메이킹 키트, 메카닉 블록 세트 등이 있어요. 직접 조립하거나 조종해볼 수 있는 제품들이 특히 좋아요. 사용법을 익히는 과정 자체가 큰 재미를 주거든요.
요즘은 유튜브나 게임 스트리머에 관심이 많은 아이도 많아서, 가볍게 시작할 수 있는 입문용 마이크, 유튜버 키트 같은 것도 핫템이에요. 단, 부모의 관리하에 사용할 수 있도록 가이드가 함께 가야 해요 📸
음악이나 그림에 흥미가 있는 친구들에겐 디지털 피아노, 타블렛, 드로잉 세트도 정말 좋은 선택이에요. 아이가 꾸준히 발전시킬 수 있는 ‘취미’를 위한 선물이 오히려 더 오래 기억에 남는 법이죠 🎵
🧩 초등 고학년 선물 TOP5 정리
| 순위 | 선물 | 특징 |
|---|---|---|
| 1위 | 프로그래밍 키트 | 코딩+조립+창작 |
| 2위 | 입문용 드론 | 조종 감각 향상 |
| 3위 | 디지털 드로잉 타블렛 | 미술 취미 발달 |
| 4위 | 유튜버 키트 | 콘텐츠 창작 입문 |
| 5위 | 전자 키보드 | 음악적 감수성 강화 |
초등 고학년쯤 되면 단순한 장난감은 잘 안 가지고 놀아요. ‘배워서 내가 직접 해볼 수 있는 것’에 흥미를 느끼기 시작하니까, 도전심을 자극하는 선물이 가장 반응이 좋더라구요 😎
13세 이상 청소년 선물 🎧

청소년기는 자율성과 개성이 강하게 드러나는 시기예요. 이 시기의 선물은 '실용성'과 '자기 표현'이 키포인트예요. 취향이 뚜렷한 나이라 무작정 귀엽거나 유행하는 선물을 고르면 만족도가 낮을 수도 있어요.
청소년에게 인기 있는 선물로는 무선 이어폰, 기프트카드(문구점, 앱스토어 등), 베이직 백팩, 독서대, 스마트 워치, 패션잡화, 방 꾸미기 아이템 등이 있어요. 특히 실생활에서 자주 사용하는 아이템이면 만족도가 높아요.
취미나 관심사에 맞춘 선물도 좋아요. 독서를 좋아하는 친구에겐 베스트셀러와 독서등을 함께 선물하거나, 음악 좋아하는 친구에겐 헤드셋이나 작곡 앱 이용권도 좋죠. "나를 잘 이해해주는 선물"이라는 느낌이 들게 만드는 게 포인트예요 🧡
디지털 기기를 활용한 자기계발도 중요해지는 시기라, 온라인 수강권이나 코딩/영상편집 교육 프로그램 등록권도 트렌디한 선물이에요. 부모님 입장에서도 교육과 실용성을 동시에 챙길 수 있어서 만족도 높아요.
🎁 13세 이상 청소년 추천 선물 TOP5
| 순위 | 선물 | 포인트 |
|---|---|---|
| 1위 | 무선 이어폰 | 일상 필수템 |
| 2위 | 기프트카드 | 자유로운 선택 |
| 3위 | 스마트 워치 | 건강+알림 기능 |
| 4위 | DIY 인테리어 소품 | 자기만의 공간 꾸미기 |
| 5위 | 온라인 수강권 | 자기계발 지원 |
청소년 선물은 ‘너의 취향을 존중해’라는 메시지를 담는 게 핵심이에요. 어떤 브랜드를 좋아하는지, 관심 있는 유튜버나 게임은 뭔지 미리 파악하면 아이의 눈이 반짝반짝해질 거예요 🤩
창의력·교육용 선물 아이디어 💡

아이들의 미래를 위한 선물을 고민 중이라면, 창의력과 교육을 동시에 챙길 수 있는 선물이 최고예요. 단순히 재미있는 장난감이 아닌, 아이가 스스로 생각하고 탐구하며 배우는 재미를 느낄 수 있게 해주는 게 포인트죠!
예를 들어, 과학 실험 키트나 입체 퍼즐, 코딩 로봇, 미술 창작 키트 같은 제품들은 아이의 두뇌를 자극하고 창의적 사고를 키워줘요. 직접 만들어보거나 조작해보는 과정이 곧 학습이 되기 때문에 몰입도도 훨씬 높아요.
또한, 요즘은 디지털 콘텐츠 활용 교육도 각광받고 있어요. 타블렛용 드로잉 앱, 프로그래밍 입문 도서, 논리 퍼즐북 등도 반응이 좋아요. 특히 문제를 푸는 과정에서 성취감을 느끼는 아이들에게 큰 자극이 되죠 🧠
창의력 선물은 아이의 흥미와 성향에 따라 고르는 게 중요해요. 미술을 좋아하는 아이에겐 미니 이젤 세트나 컬러링 북, 과학을 좋아하는 아이에겐 스마트显微镜 같은 탐구형 아이템이 제격이에요!
📚 창의력·교육용 선물 TOP5 아이디어
| 순위 | 아이템 | 효과 |
|---|---|---|
| 1위 | STEAM 과학 실험 키트 | 탐구력, 실험 감각 |
| 2위 | 프로그래밍 로봇 | 논리적 사고력 향상 |
| 3위 | 디지털 드로잉 타블렛 | 미술 감각과 창의력 |
| 4위 | 3D 입체 퍼즐 | 공간 인지력, 집중력 |
| 5위 | 미니 건축 블록 | 구성 능력, 창의력 발달 |
창의력과 교육이 결합된 선물은 단순한 재미를 넘어서 아이의 잠재력을 깨우는 데 큰 역할을 해요. 그래서 요즘 부모님들 사이에서도 인기 많고, 아이들도 몰입도가 높아서 만족도 최고예요! 😄
FAQ
Q1. 어린이날 선물은 언제 사는 게 가장 좋을까요?
A1. 최소 일주일 전에는 준비하는 게 좋아요. 온라인 쇼핑 시에는 배송 지연을 고려해 더 일찍 사는 걸 추천해요.
Q2. 어린이날 선물로 너무 비싼 건 부담일까요?
A2. 금액보다는 아이에게 의미 있는 선물인지가 더 중요해요. 아이와의 대화나 관심사를 반영하는 게 훨씬 좋아요.
Q3. 학습용 선물만 고르면 아이가 싫어할까요?
A3. 맞아요, 재미 요소가 없으면 거부감이 생겨요. 학습과 놀이가 결합된 창의형 제품이 좋답니다.
Q4. 아이에게 먼저 선물 선택권을 주는 게 좋을까요?
A4. 사전 질문이나 선호도 조사를 통해 아이가 좋아할 방향으로 유도해주는 게 효과적이에요.
Q5. 손주 선물은 어떤 게 좋을까요?
A5. 실용성과 정서적 가치를 함께 담을 수 있는 성장기록 아이템이나 가족과 함께하는 보드게임이 좋아요.
Q6. 형제자매가 있을 경우 선물은 어떻게 골라야 하나요?
A6. 나이와 성향에 맞게 각각 준비하되, 한 가지는 같이 할 수 있는 활동형 선물을 추가하는 것도 좋아요.
Q7. 유행하는 어린이 선물은 뭐가 있어요?
A7. 코딩 로봇, 유튜버 키트, 미니 드론, 스마트 워치 등이 요즘 아이들에게 인기가 많아요.
Q8. 선물 포장은 꼭 해야 하나요?
A8. 선물의 설렘은 포장에서 시작돼요. 아이 눈높이에 맞는 캐릭터 포장이나 상자만으로도 기대감을 높일 수 있어요 🎀
태그:어린이날선물, 나이별추천, 창의력선물, 교육용장난감, 청소년선물, 유치원선물, 초등학생선물, 드론, 유튜버키트, 코딩로봇
'정보' 카테고리의 다른 글
| 어버이날 10만원대 최고의 선물 (0) | 2025.04.06 |
|---|---|
| 어린이날 서울·경기 체험 명소 총정리 (0) | 2025.04.06 |
| 40-50대 자녀 학비 세금 혜택 총정리 (0) | 2025.04.06 |
| 이혼·부모 부양 시 세금 문제 해결법 (0) | 2025.04.05 |
| 50대가 놓치기 쉬운 세금 환급 3가지 (0) | 2025.04.05 |
댓글